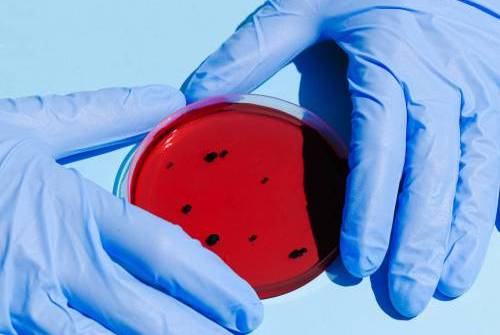

Colaboramos con los prestigiosos laboratorios Synlab. Con el fin de brindar un servicio integral a nuestros clientes, nos complace informar que podemos ofrecer la conveniencia de extraer muestras y sangre para su análisis en los laboratorios de Synlab.
Nuestro equipo de enfermeras altamente capacitadas garantizará una extracción de muestras profesional y cómoda, asegurando que los resultados de los análisis se obtengan de manera eficiente y precisa.
Esta colaboración nos permite ofrecer una atención integral y completa a nuestros clientes, combinando nuestros servicios especializados con los servicios de diagnóstico confiables y de alta calidad de Synlab.
Juntos, nos esforzamos por brindar a nuestros clientes una experiencia de atención médica integral y de excelencia.
Estos servicios, entre otros, son:
MyBIOME

El test de microbioma intestinal más avanzado del mercado que permite ofrecer una visión detallada e integral de tu microbioma intestinal y de cómo esta interacciona con tu salud.
Sensibilidad Alimentaria A200

Evalúa la respuesta de nuestro sistema inmune frente a más de 200 alimentos habituales en la dieta mediterránea.
Perfil Vegetariano

Evaluación de parámetros que pueden verse alterados en una dieta vegetariana para poder adaptar la dieta y prevenir o corregir cualquier alteración.
Perfil Vegano

Parámetros que pueden alterarse en una dieta vegana y así poder adaptar la dieta y prevenir o corregir cualquier alteración.
Nutricional Avanzado

Estudio integral para una nutrición personalizada que, a través de un análisis genético y de diferentes parámetros bioquímicos relacionados con tu metabolismo y nutrición, permite determinar la alimentación más apropiada para ti.
Migratest

Evaluación de la actividad de la enzima DAO, valorando tanto su concentración como su actividad, para determinar si tu migraña se debe a un déficit de esta sustancia.
Chequeo completo Mujer

Análisis de indicadores claves para la valoración del estado de salud general de la mujer.
Chequeo completo Hombre

Análisis de indicadores claves para la valoración del estado de salud general del hombre.
Refuerzo inmunitario

Evaluación de los niveles de las vitaminas y minerales más involucrados en la respuesta inmunitaria, lo que te permitirá chequear estos nutrientes clave y conocer cómo asegurar un aporte adecuado para fortalecer tus defensas.
Test del Aliento

Es una prueba funcional para evaluar la presencia de Sobrecrecimiento Bacteriano en el Intestino Delgado (SIBO) o determinadas intolerancias alimentarias a carbohidratos.
BRCA+16 genes
Test genético de predisposición hereditaria a cáncer de mama, ovario y endometrio que proporciona información de alta fiabilidad sobre el riesgo de padecer estos tipos de cáncer.
Valoración del estrés

Permite una evaluación de los niveles de cortisol

